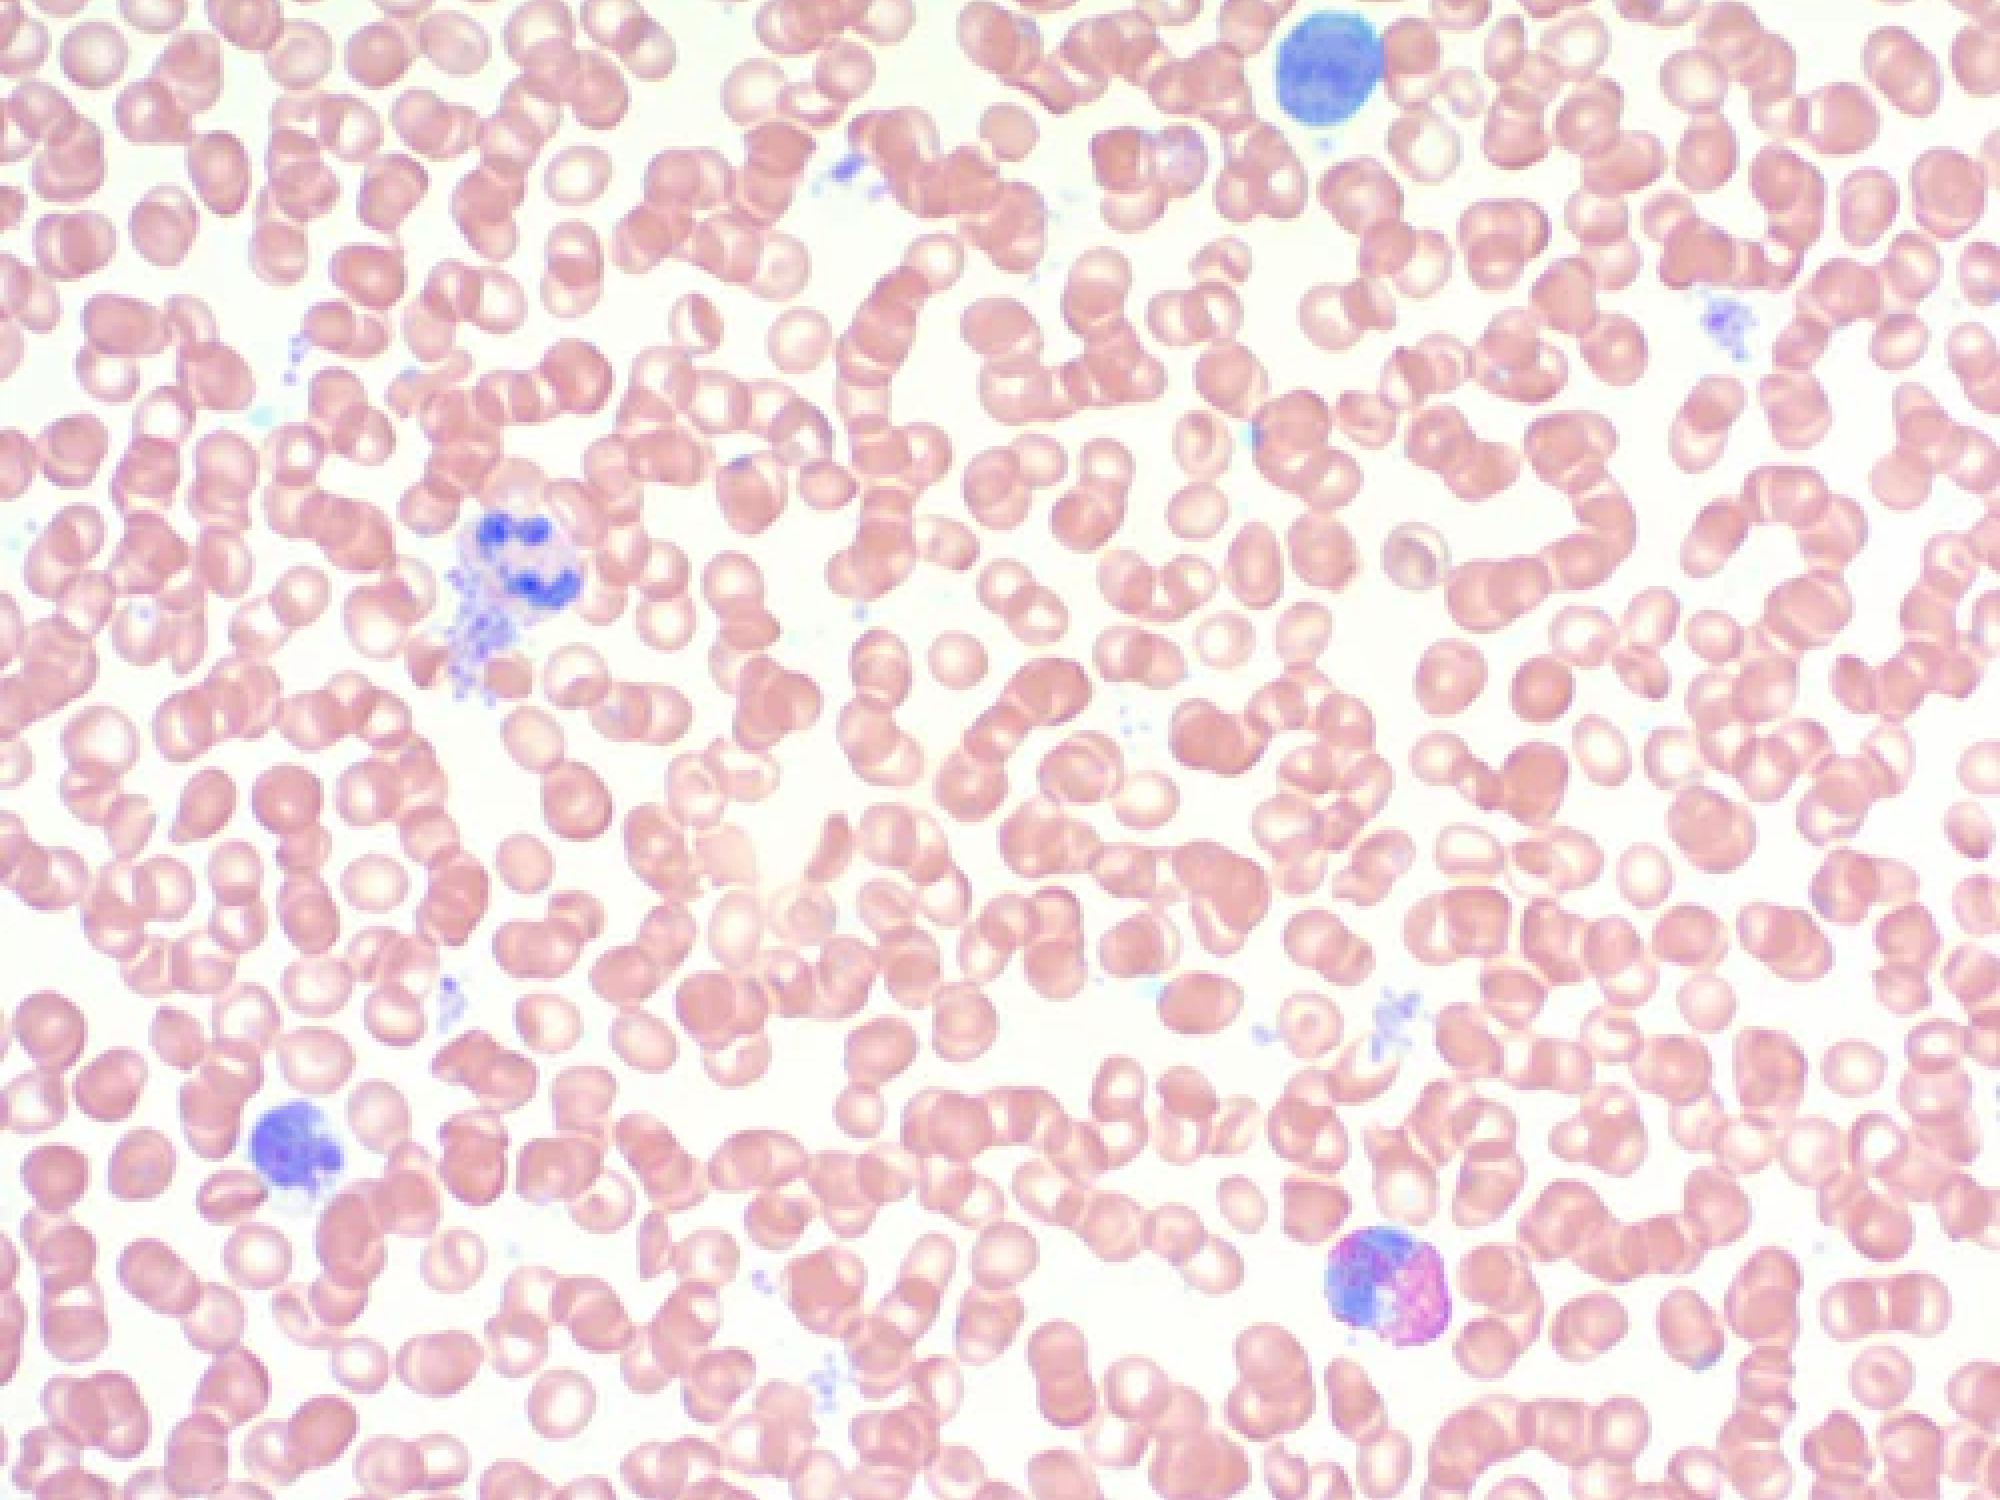
Giemsa Stain Kit (May-Grunwald)

Special Stains
Acid Fast Bacteria (AFB) Stain Kit
Sale priceFrom $61.71
Colloidal Iron Stain Kit
Sale priceFrom $84.84
Elastic Stain Kit (Modified Verhoeff's)
Sale priceFrom $104.91
Glycogen, Elastin, Mucin Stain Kit
Sale priceFrom $114.17
GMS Stain Kit
Sale price$209.85
GMS Stain Kit with Periodic Acid
Sale price$209.26
H. Pylori Rapid Stain (1-Step)
Sale priceFrom $20.07
H. Pylori Rapid Stain Kit
Sale priceFrom $132.69
Hematoxylin and Eosin Stain Kit
Sale priceFrom $52.33
Iron Stain Kit
Sale priceFrom $80.23
Jones Methenamine Silver Stain Kit (For Basement Membrane)
Sale price$388.78
Lieb's Crystal Violet for Amyloid (0.5%)
Sale priceFrom $88.63
Movat Pentachrome Stain Kit (Modified Russell-Movat)
Sale priceFrom $219.09
Mucicarmine Stain Kit (Modified Southgate's)
Sale priceFrom $89.49